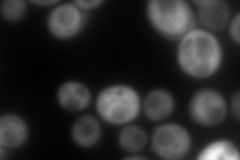
YKL035W
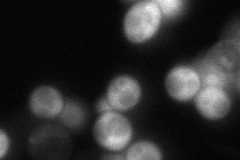
YKL035W

View description
UDP-glucose pyrophosphorylase (UGPase), catalyses the reversible formation of UDP-Glc from glucose 1-phosphate and UTP, involved in a wide variety of metabolic pathways, expression modulated by Pho85p through Pho4p
Localization:
Intensity:
Fold change:
Significance:
-
C’ GFP library in SD

below threshold17.22 -
N' NOP1pr-GFP in SD

cytosol179.43 -
N' TEF2pr-mCherry in SD
below threshold228.309 -
N' NATIVEpr-GFP in SD
cytosol26.7444 -
N' TEF2pr-VC and Cyto-VN in SD

#N/A0 -
C’ GFP library in SD+DTT

cytosol16.690.96No -
C’ GFP library in SD+H2O2

cytosol15.160.87No -
C’ GFP library in Starvation Media

cytosol13.080.75No -
C’ GFP library on the background of Pup2-DaMP

below threshold -
C’ GFP library on the background of CCT mutant

below threshold18.41091.06868No
